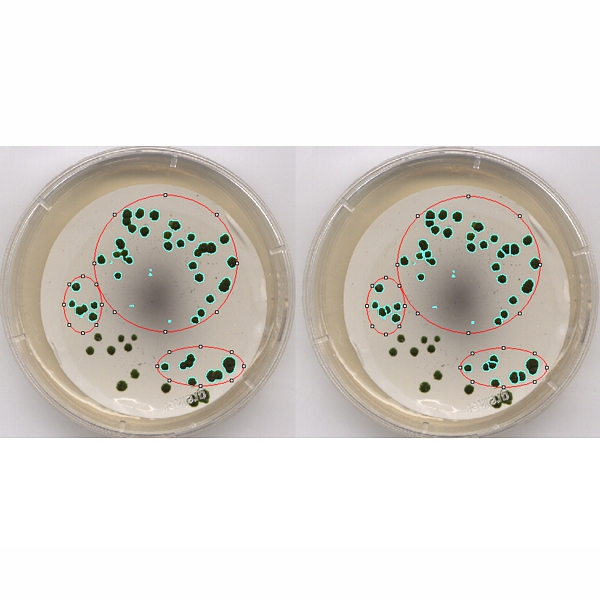
Software LABIMAGE CC Detalhe
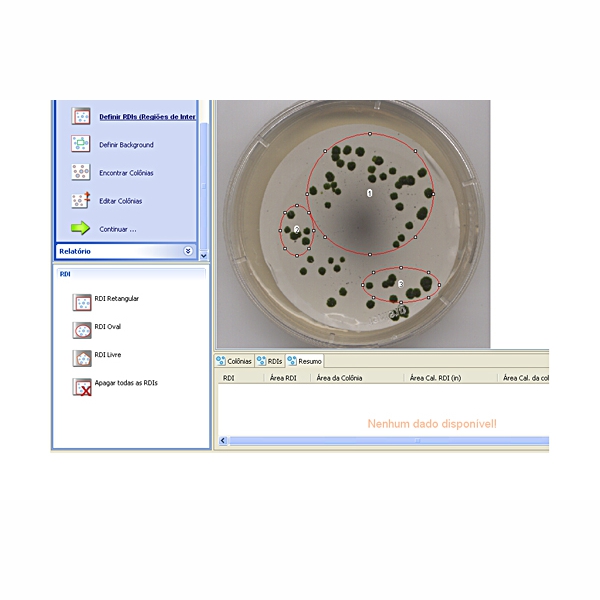
Software LABIMAGE CC

Descrição
Software para contagem automatizada de colônias de bactérias em imagens digitais.
Software LabImage CC para análise de imagens de placas de colônias.
Desenvolvido pela Loccus em parceria com empresas da Europa, o LabImage CC dispõe de ferramentas que guiam os usuários nas análises, algoritmos de análise e relatórios para suprir a necessidade de documentação dos dados gerados.
Contagem de colônias automatizada.
Plataforma totalmente em Português. Determinação do número e área de cada colônia. Possibilita exportar a tabela de resultados para o programa Excel e a figura original para qualquer programa de imagem. Exporta relatórios completos e personalizáveis para documentação dos dados gerados
O LabImage CC atende às normas da FDA (U.S. Food and Drug Administration) CFR Part 11.
________________________________________
CARACTERÍSTICAS
Fluxo de trabalho guiado
O LabImage CC auxilia a sua análise de imagem com um fluxo de trabalho passo-a-passo.
Diferentes formatos de RDI
O LabImage CC oferece 3 opções de formato de regiões de interesse. A RDI poligonal permite que você defina formas irregulares facilmente. Você pode usar RDI´s de diversos formatos diferentes em uma só imagem.
Definição de background
Define facilmente a área de background através do histograma. Com a ajuda dos controles de escala de cinza você pode otimizar os resultados da detecção.
Detecção de colônias
Economize o tempo gasto com contagens manuais. O LabImage CC detecta colônias automaticamente em segundos. Com os parâmetros ajustáveis e os canais de extração é possível otimizar a detecção.
Separação automática
A separação automática ajuda você a separar colônias agrupadas. Após a separação a tabela de dados é atualizada automaticamente. Você também pode separar colônias manualmente traçando uma linha divisória.
Exportar
Mostre seus resultados para outras pessoas. Você pode exportar os dados de sua medição em formatos comuns para outras aplicações.
O LABIMAGE CC INCLUI:
- CD de instalação
- 1 chave da licença